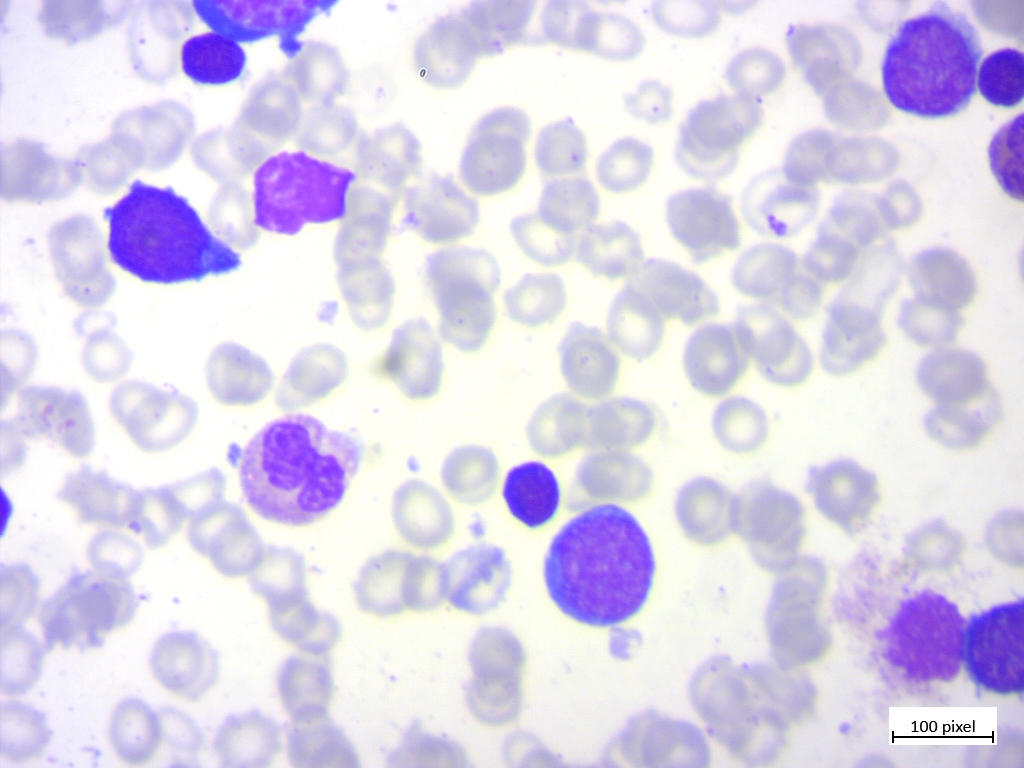
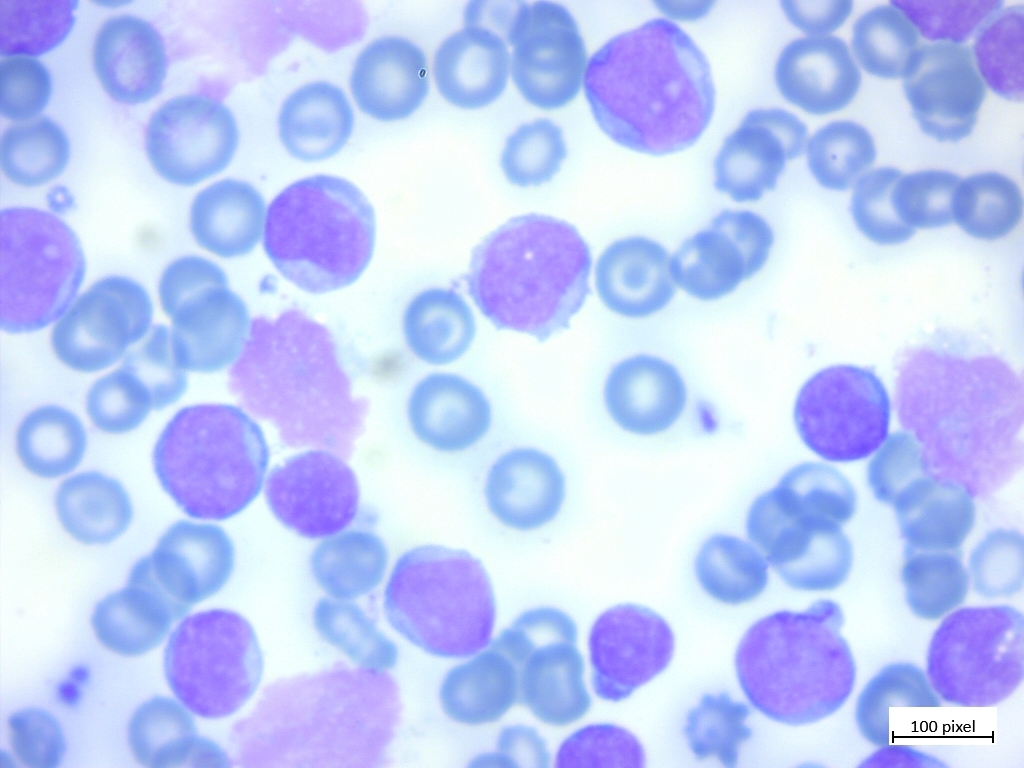
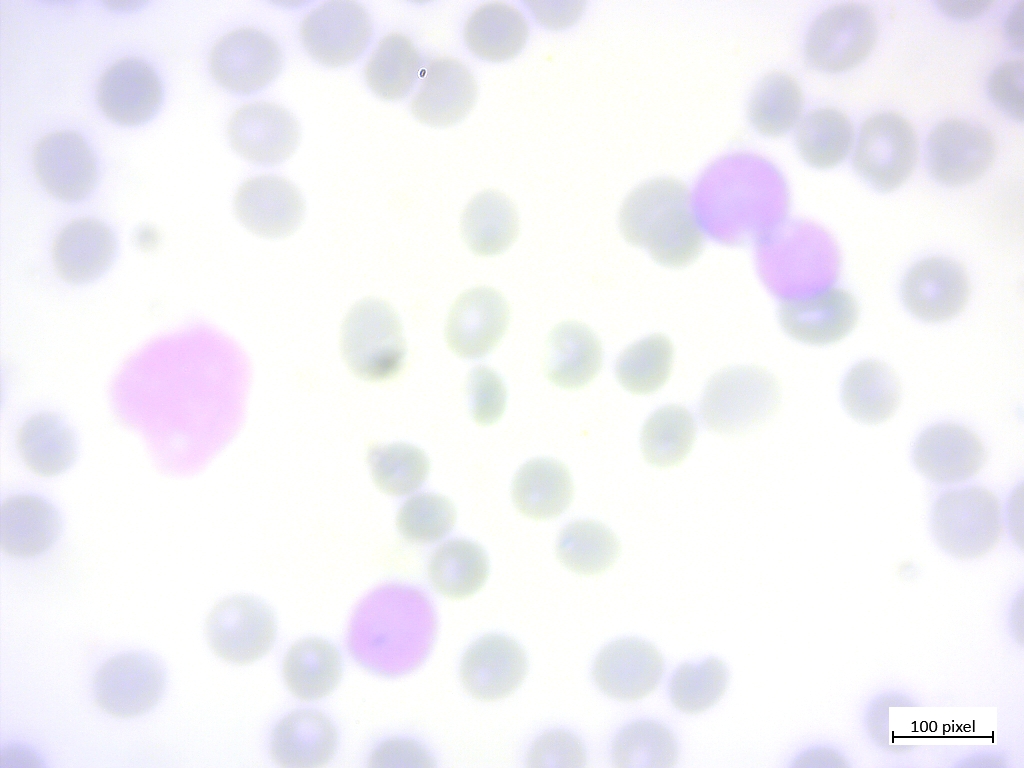

Testing Model: Blood Cancer Cells
Classifies blood cancer cells
Trained on: 3,242 images
Try a sample image (drag it into the box):
Benign

Malignant early Pre-B
Malignant Pre-B
Malignant Pro-B